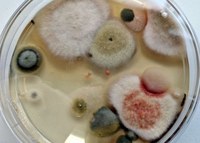
Pilze, durch Auslegen von speziellen Agarplatten an der frischen Luft quasi
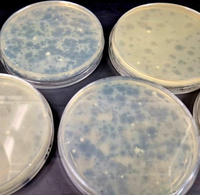
Bakterien wurden von spreziellen Viren infiziert und zerstört

Header Mikrobiologie Labor
Mikrobiologie Labor

Profil und Zielsetzung
Mikrobiologische Arbeitsmethoden werden vermittelt. Ein besonderer Augenmerk gilt der sterilen Arbeitsweise. Die Bedeutung unterschiedlicher Nährböden, die Kultivierung und die quantitative Erfassung von Mikroorganismen wird verdeutlicht.
Lerninhalte
- Herstellung von Nährmedien
- Versuche zu Keimbelastung und Sterilisation
- Bestimmung von Keimzahlen
- Anreicherung und Isolierung spezieller Mikroorganismen
- Untersuchung fixierter und gefärbter Bakterien
- Antibiotikawirkung
- Bestimmung der Zitronensäureproduktion durch Aspergillus
- Identifikation von Mikroorganismen

Versuche
Die Studierenden bereiten sich anhand eines Skriptes auf die Versuche vor.
Die Durchführung erfolgt weitgehend selbstständig. Da mit Umweltproben gearbeitet wird, sind besondere Sicherheitsmaßnahmen einzuhalten.
Grundmethoden der Mikrobiologie
- Steriles Arbeiten
- Mikroskopie
- Unterschied Gesamtzellzahl und Lebendzellzahl
- Charakterisierung und Identifizierung von Organismen
Verfahren zur Keimreduktion
- Thermisch
- Enzymatisch
- Physikalisch
Wasseruntersuchung
- Anreicherung, Isolierung und Identifikation von Coliformen aus See-/Flusswasser
- Nachweis von Coliphagen im Abwasser
Aufnahme einer Wachstumskurve von Vibrio natriegens
Ausstattung
- verschiedene Mikroskope
- Sterilwerkbank
- Autoklav
- Colony Counter
- Thoma-Zählkammer
- Klimaschränke
- allgemeine Laborausstattung